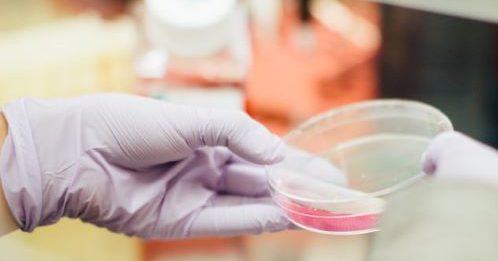

Program Highlights
Biology is the science of life. You will study fundamental concepts of life and its different forms, from simple microbes to highly complex animals and plants. Through lessons carefully planned by experienced faculty, you will learn about genetics, cellular and molecular biology, morphology (form) and physiology (function), development, and ecology. As a Mount student, you will also enjoy a close-knit community of students and faculty, small class sizes, and life in Halifax. View Biology courses »
Program Options
(PDF of the department brochure)
Biology students will graduate with a BSc or a BSc Honours degree after four years of study. Biology may also be taken as a combined major, concentration or minor. You will develop a solid background in natural sciences such as chemistry and physics as well as transferable skills like:
- Analytical and scientific thinking
- Problem solving
- Analysis and interpretation of data sets
- Summarizing data and communicating results through written reports or verbal presentations
Visit the complete program description »
Interested in Honours?
Before committing to a field of specialization and starting a thesis project, you will have the opportunity to conduct directed research projects with Mount faculty to get better insight in the field of research. Areas of specialization in research groups at the Mount include plant biology, animal science and microbial biology. Read more »
**Application deadline for admission to honours 2026-2027: March 1, 2026**
For more information, contact biology@msvu.ca